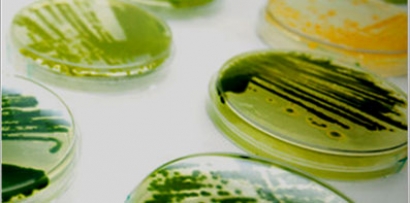
Endesa quiere producir en Almería microalgas que capturan CO2

Algavillage, empresa constituida por la compañía de capital británico Firglas y Biorizon Biotech, invertirá más de 3 millones de euros en la construcción de una planta de microalgas para su explotación "por un periodo de 10 años con posibilidad de renovación". Según explica en un comunicado Endesa (la compañía italiana que pertenece al Grupo Enel), la planta de microalgas de la central de Carboneras, con 1.500 metros cuadrados de extensión, lleva 15 años investigando las aptitudes de las microalgas para la captura y fijación de CO2 y, así mismo, su interés para el sector alimentario. Las microalgas -añaden desde Endesa- son un "súperalimento", que proporciona "numerosos beneficios para la salud, entre los que destaca su contenido en ácidos grasos poliinsaturados Omega-3". Además, frente a otras fuentes de Omega-3, las algas presentan una cierta ventaja, según la compañía: cuando obtenemos estos ácidos de fuentes como el pescado, se generan muchos subproductos; cuando se obtienen de las algas, los "residuos" son mucho menores.
Endesa ha participado en diferentes proyectos de investigación a escala europea nacional. Uno de ellos ha sido Algae for Healthy World, consorcio para producir biocompuestos de microalgas con aplicaciones alimentarias constituido por Ainia, el Centro de Investigaciones Biológicas (CSIC-CIB), Mar Cristal Marilum, Neoalgae Micro Seaweeds Products, Novatec y la Universidad de Cádiz. El objetivo de esta iniciativa ha sido "desarrollar las herramientas biotecnológicas necesarias para mejorar y optimizar la producción de biomasa de origen marino".
Futur-e
Endesa puso en marcha en 2020 el Plan Futur-e para esta instalación. El objetivo de este Plan es mitigar el impacto que los cierres de centrales de como la de Litoral puedan tener sobre la población local. El Plan opera en torno a cuatro ejes: búsqueda proactiva de empleo; fomento de la actividad económica en la zona; formación y capacitación de la población local; e iniciativas de sostenibilidad del municipio. Pues bien, con ese horizonte -el de mitigar el impacto del cierre de la central de Carboneras (Almería)-, la compañía italiana, y aparte del acuerdo con Algavillage, ha lanzado un concurso internacional de búsqueda de proyectos para "el desarrollo económico e industrial en los terrenos de la Central Térmica Litoral de Carboneras y de su terminal portuaria, una vez se ejecute su cierre y desmantelamiento".
Este concurso se encuentra en la actualidad en su fase de evaluación con la constitución de la mesa de trabajo que analizará la viabilidad de las 14 propuestas presentadas.
Además, ha anunciado que instalará unos 1.200 megavatios de potencia renovable, principalmente fotovoltaica, que sustituirán a los 1.159 megavatios de potencia de la central térmica Litoral.
Protagonistas
Biorizon Biotech es una empresa enfocada en el campo de la biotecnología. Sus estudios y desarrollos -informa Endesa- se han centrado en las innumerables aplicaciones de las microalgas, cianobacterias y bacterias en el campo de la agricultura intensiva y ecológica, desarrollando técnicas y procesos para la mejora del crecimiento de plantas y frutos y bioplaguicidas que sustituyan a los actuales productos químicos. Cuenta con distintas instalaciones, donde destaca Ágora-Sabana, la mayor planta de Europa de cultivo de microalgas bajo techo enfocada a aplicaciones agrícolas. También dispone de plantas de procesado y elaboración de sus productos para la agricultura y alimentación animal.
Firglas es una empresa promotora y constructora de instalaciones industriales de producción de microalgas y bacterias con sede en Londres, con un historial de inversiones -informa Endesa- de más de 150 millones de libras en este campo.
Firglas y Biorizon Biotech han constituido Microalgas Carboneras SL, con nombre comercial Algavillage, para llevar a cabo estas instalaciones de producción.

